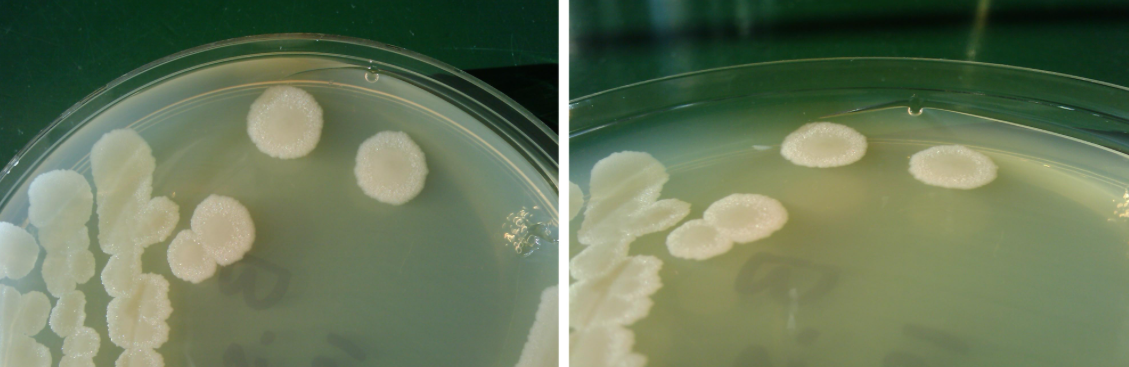
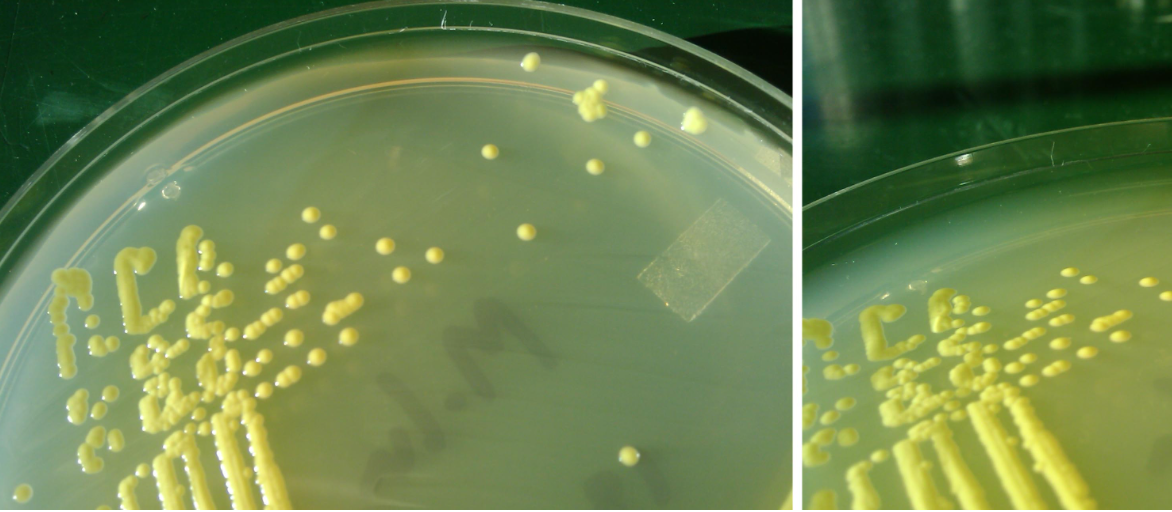
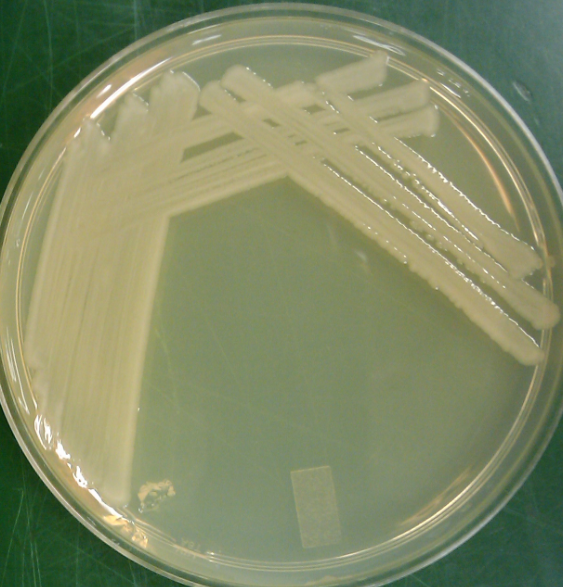
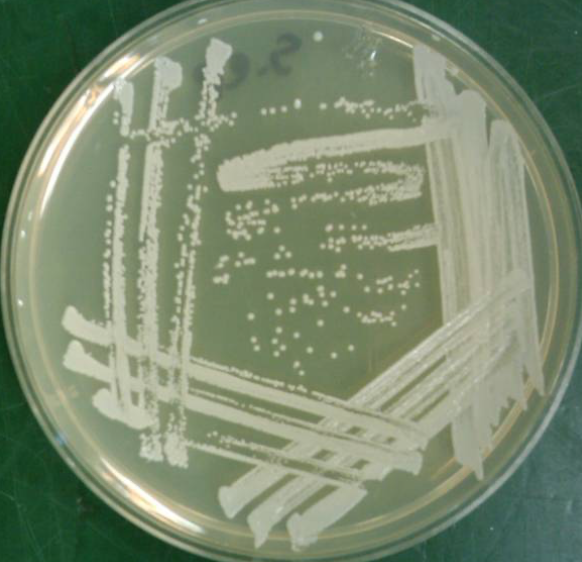

Compound microscope
Uses two sets of lenses to magnify specimen -
- ocular (10x)
- objective (10x100x)
Total magnification
ocular x objective
brightfield microscopy
image of the specimen appears in light illuminate background
What is brightfield good for
observing coloured specimens but not good for unstained
Fill in the blanks and label specifics

Condenser - focuses light to illuminate specimen (Close to the stage as possible)
Iris - controls the width of light passing through the condenser

Using the iris diaphragm
opened = to see vibrant colours
closed = improves contrast in colourless specimens
What if the brightness is too high for your image
use the light source control knob, NOT the condenser or iris
When and why should you use oil immersion
100x magnification
- oil makes sure that the light passing through enters the objective and isn’t refracted away
parfocal
specimen remaines in focus at new magnifications
What is this and how can you tell
bacteria
- very small cells
- cocci, rod and
Can you tell the diff between archaea and bacteria

- naur, only cell wall composition
archaea - larger than bacteria
what is this and how can u tell

cyanobacteria
- colour
- much larger than bacteria and archaea
- 2 greens are heterocysts

Euglena
- eukaryotes
- larger
- you can see the membrane bound organelles
- motile, photosyntehsis

Saccharomyces cervisiae - fungi - yeast
- has membrane bound organelles
- cells are colourless so iris was partially closed
-

Penicilin -fungi - mold
- conidia - branches on the end - asexual spores

prokaryote - no membrane bound organelles
- cyanobacteria
- arrow is heterocysts(for nitrogen fixation)
what kind and how do microbes grow on t-soy plates
heterotrophic microbes
- absorbs nutrients out of the solid plate beneath them




describe the colonies
wrinkled, flat, undulate, white, opaque dull
circular, umbonate, entire, yellow, opaque glossy
isolating colonies is good for
- to see whether or not a culture is pure
- obtain a pure culture
- observe colony characteristics
- pick a single well-isolated colony to begin new experiments
Whats wrong with this and how to fix it
Most likely forgot where the last set of streaks were so you didnt streak it when you went into the last section.
Put the plate in the light to see where u streaked last
Whats wrong with this and how to fix it
You streaked the last streak into the first streak so you couldn’t get well isolated colonies.
look in the light to see!




























